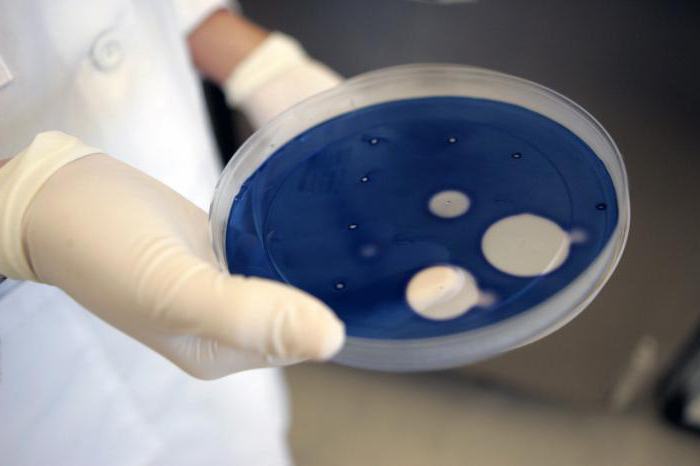
ce que vous devez prendre pour devenir un spécialiste en médecine légale

Aujourd'hui, de nombreux diplômés se demandent comment devenir un scientifique légiste. C'est un métier plutôt prestigieux et intéressant, qui permet de se développer, ouvrant la voie à une croissance de carrière. Naturellement, pour commencer, il vaut la peine d’en apprendre davantage sur la profession elle-même et sur l’éducation appropriée.
Bref historique

Avant de réfléchir à la question de savoir comment devenir un scientifique légiste, il est utile d’en apprendre davantage sur ce métier.
En fait, la procédure, qui ressemble à un examen médico-légal moderne, est apparue avant notre époque. Hippocrate, dans ses ouvrages, a expliqué comment, par exemple, lors de l’examen du corps d’une personne assassinée, il est possible de déterminer quelle blessure a causé la mort.
Le terme lui-même a été introduit beaucoup plus tard. Son auteur était Hans Gross, considéré comme le fondateur de la criminalistique moderne. Le terme vient du mot latin crimen, qui signifie «crime» en traduction.
Cette industrie a commencé à se développer activement dans la seconde moitié du XIXe siècle, au cours de laquelle le crime organisé a commencé à se renforcer. À cette époque, des médecins, des chimistes, des physiciens et d'autres scientifiques capables de fournir un point de vue d'expert étaient impliqués dans le processus d'enquête. La criminalistique est une industrie en constante évolution, qui utilise les réalisations de la science et de la médecine modernes.
Comment devenir criminaliste en Russie? Les exigences de l'éducation

Si vous souhaitez travailler dans ce domaine, vous devez d'abord suivre un enseignement approprié et, dans la plupart des cas, juridique.
L’Académie d’État de Moscou, l’Université du Ministère de l’intérieur à Moscou et à Saint-Pétersbourg, l’Institut de droit Saratov du Ministère de l’intérieur, ainsi que l’Académie du Ministère de l’intérieur à Volgograd offrent aux requérants une spécialité telle que la médecine légale.
Que devez-vous prendre pour devenir un scientifique légiste? La liste des examens ou des disciplines de l'examen dépend en grande partie des exigences de l'établissement d'enseignement choisi. En règle générale, les candidats passent un examen de russe et de sciences sociales, d'histoire. De nombreuses institutions exigent des candidats qu'ils se soumettent à une commission médicale et qu'ils se conforment à diverses normes sportives, le travail d'un criminaliste étant plus ou moins lié à l'activité physique et à la résistance au stress.
Au cours de la formation, le futur expert devra étudier en profondeur l’affaire pénale, la méthodologie de recherche en laboratoire, le profil et la théorie générale de la criminalistique, ainsi que les règles de collecte de preuves et de preuves. Les étudiants étudient également des disciplines telles que la théorie et la pratique du processus pénal, les possibilités modernes de l'examen médico-légal, etc.
Cours spécialisés

Que faire si une personne a déjà une éducation? Par exemple, comment un médecin peut-il devenir un médecin légiste? Dois-je retourner au collège et étudier quelques années de plus? En fait, il existe une autre option: vous pouvez suivre des cours spécialisés d’examen criminel. Cela vaut la peine de dire qu’une telle formation dure au moins trois mois, au bout desquels vous devez effectuer un stage. Bien entendu, la présence de l'enseignement supérieur est obligatoire dans ce cas.
Les principaux domaines de la médecine légale

Vous savez déjà comment devenir un expert en médecine légale. Mais cette profession a des directions différentes et chaque étudiant qui étudie au département de criminologie médico-légale devra choisir ce qu'il fera à l'avenir. Les zones suivantes sont disponibles:
- balistique - une industrie qui se consacre à l’étude des armes à feu, aux comparaisons et aux méthodes d’utilisation de différents modèles;
- trasologie - implique une recherche approfondie et une étude des traces laissées sur les lieux du crime;
- Empreinte digitale - le domaine de la criminalistique, qui aide à établir une personnalité en analysant les empreintes digitales;
- la phonoscopie est une industrie qui étudie des informations sonores;
- graphologie - dans ce cas, les spécialistes étudient l'écriture manuscrite;
- Empreintes génétiques - directive comprenant une étude détaillée des traces organiques sur les lieux du crime, y compris des échantillons de sang, de la salive et d'autres liquides internes.
En fait, il y a beaucoup plus de directions (environ 20 espèces). Bien entendu, les compétences requises dans une affaire donnée dépendent en grande partie de la nature du crime. Chaque type d’examen implique l’utilisation de certains outils, techniques et directives. C'est pourquoi il est presque impossible d'être un scientifique médico-légal absolument universel.
Néanmoins, les spécialistes dans ce cas peuvent être de deux types.
- Les experts légistes universels sont une sorte de première instance dans toute enquête. Ces spécialistes sont les premiers à arriver sur les lieux du crime, à recueillir des preuves, à prendre des photos, etc.
- Par la suite, les preuves ou traces obtenues sont généralement transférées à des spécialistes du profil étroit qui mènent déjà des études plus précises et complexes (par exemple, analyses de sang, analyses d’ADN, études d’écriture manuscrite, etc.).
Responsabilités médico-légales
Après avoir abordé la question de savoir comment devenir un expert en criminalistique, il convient de prêter attention aux devoirs directs des travailleurs de cette profession.
- En règle générale, l'expert médico-légal se rend sur les lieux du crime et procède à un examen. Ses responsabilités incluent également la recherche et la correction de toutes traces et preuves éventuelles, la photographie du lieu.
- À l'avenir, une analyse des informations trouvées (y compris des tests de laboratoire) et une reconstruction des événements possibles sont effectuées.
- Le spécialiste élabore également un plan de recherche et aide à formuler une hypothèse de travail.
- Les criminologues effectuent une analyse des traces du suspect et établissent un lien entre le criminel et les preuves.
- Bien entendu, l’éventail des tâches d’un spécialiste inclut l’élaboration d’un protocole de ses propres activités.
Que faut-il pour devenir criminaliste? Qualités personnelles

Tout le monde ne peut devenir un bon spécialiste dans ce domaine. C'est un métier sérieux, qui exige de la personne certaines qualités.
On pense que des qualités telles que la curiosité et la confiance en soi n’interfèrent pas avec un expert expérimenté. Cependant, une personne doit nécessairement être bien érudite, car le travail exige un bagage énorme de connaissances scientifiques. Naturellement, un professionnel doit être rationnel, méthodique, avoir une bonne mémoire et être capable de se concentrer sur un objet particulier pendant une longue période. L'important est la résistance au stress et la stabilité émotionnelle.
Lieu de travail et perspectives
De nombreux demandeurs se demandent comment devenir un expert légiste de la police. En fait, ce travail peut être obtenu presque immédiatement après l'obtention du diplôme et le stage. Bien entendu, les policiers peuvent compter sur de bons revenus et sur les prestations du gouvernement.
En outre, une telle profession offre une opportunité de développement de carrière. Par exemple, de nombreux criminologues sont mutés au bureau du procureur, puisqu’une connaissance précise de l’examen médico-légal permet de construire correctement la ligne de poursuites et d’évaluer telle ou telle preuve.
Certains criminologues construisent une carrière dans les activités de recherche opérationnelle - leurs efforts dans cette affaire visent à rechercher des criminels fugitifs, des personnes disparues, etc. Si vous le souhaitez, vous pouvez obtenir un emploi dans l'un des laboratoires médico-légaux privés.
En ce qui concerne les salaires, le chiffre exact dépend de nombreux facteurs, notamment la disponibilité de l'expérience, des compétences, des qualifications et de certaines qualités personnelles. Par exemple, en début de carrière, un spécialiste inexpérimenté peut compter sur 10 000 à 25 000 roubles par mois. Un criminaliste professionnel gagne en moyenne environ 35 à 60 000 personnes. S'il s'agit de travailler dans un poste de direction ou dans le secteur privé, vous pouvez compter sur 70 000 roubles ou plus.
Inconvénients de la profession

Compte tenu de la question de savoir comment devenir un criminaliste, il convient de prêter attention aux faiblesses de la profession. Bien entendu, les spécialistes peuvent compter sur de bons revenus et des bonus agréables. Mais n'oubliez pas que l'employé devra régulièrement se rendre sur les lieux du crime, parfois horribles. La pression d’éléments criminels n’est pas exclue. C'est un métier relativement dangereux, qui ne convient pas à tout le monde.